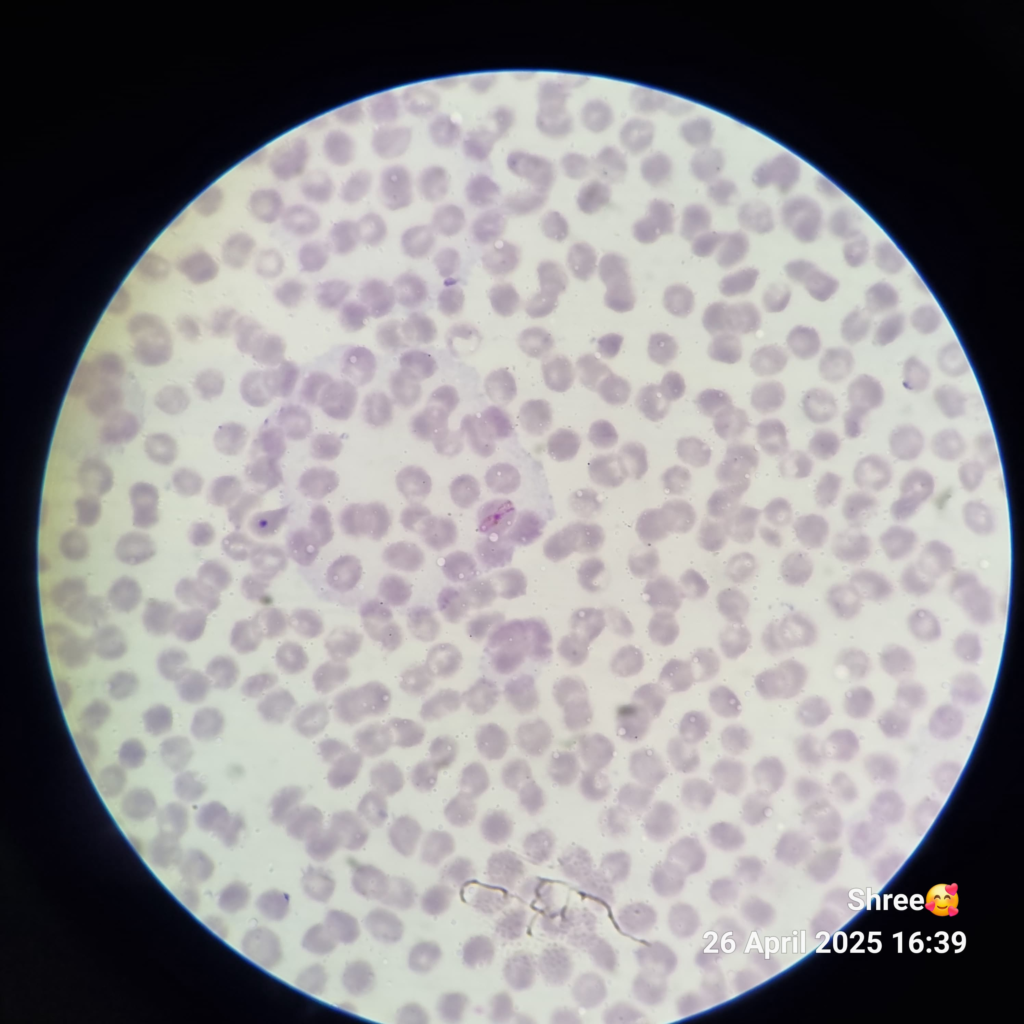
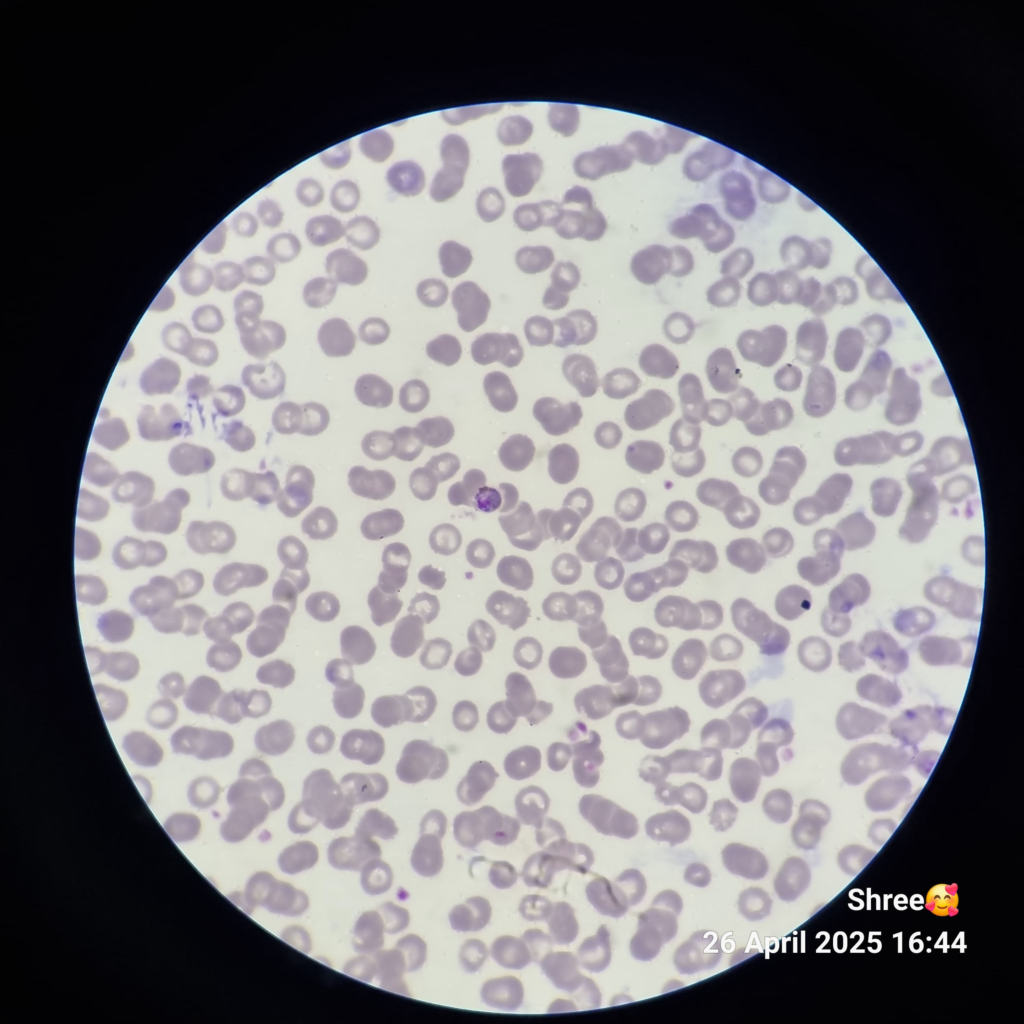

Morphology of Plasmodium Malariae
This parasite was discovered by Laveran in the year 1881.
It produces quartan malaria in humans. Quartan malaria means the fever comes after every 72 hours.

The following stages are found in P. malariae:
1) Ring (Young Trophozoite)
- The parasite shows a special tendency to invade mature and older erythrocytes.
- The young ring, or trophozoite, forms are about the size of, or are slightly smaller than, those of P. vivax.
- The chromatin is solid and red in color.
- The cytoplasm is compact, thick, and blue in color.
- Dark brown pigment is present all over the cytoplasm.
- The parasite covers one-fourth (1/4) of the RBC.
- The RBC remains the same size.
2) Trophozoites
- In this stage, the chromatin is semicircular.
- The cytoplasm is band-shaped.
- Trophozoites can also appear as a “basket form” with an oval shape.
- Parasites may grow into wide-band forms or may have rounded shapes.
- Dark brown pigments are present over the cytoplasm.
- Stipplings are present and are also known as ‘Ziemann’s dots.’
3) Mature Schizont

- In this stage, the divided chromatin surrounded by cytoplasm is known as merozoites.
- Usually 8 merozoites are present in P. malariae.
- Pigments are present or occur centrally.
- The schizont stage is a “rosette form,” where merozoites arrange themselves around the perimeter of the cell.
4) Male Gametocyte
- P. malariae seems to have fewer gametocytes than the other two species, P. vivax and P. falciparum.
- The chromatin is diffused and oval in shape.
- Dark brown pigment is present all over the cytoplasm.
- The male gametocyte is smaller than the female gametocyte.
5) Female Gametocyte
- The chromatin is compact.
- The female gametocyte is always bigger than the male gametocyte.
Infected RBC
- Infected RBCs are not enlarged.
- They are often senescent (older) RBCs and may be slightly smaller than normal RBCs.













